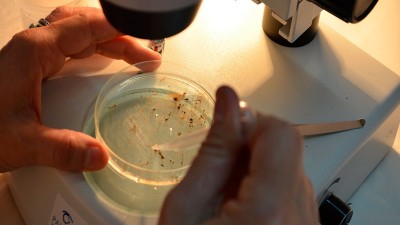
Epidemiologia brindó detalles relevantes sobre dengue

Febrero, se moderó la caída de la faena de hacienda
En este día lunes el periodista agropecuario Raúl Rusteholz, inició su programa con la editorial semanal la cual se refirió a la faena de hacienda y precios.
Epidemiologia brindó detalles relevantes sobre dengue
En la mañana de hoy viernes dialogamos con Jerónimo Amatti, médico veterinario de Epidemiologia de la Provincia de entre Ríos, quien brindó información relevante sobre el dengue
Iniciarán el Taller de Cultivo Natural Encuentro en la Huerta
Será este lunes 4 de marzo, y se trata del taller que ofrece la Municipalidad de Valle María para aquellos interesados en desarrollar este aprendizaje en contacto con la tierra y la naturaleza.
Comienzan los talleres municipales deportivos
Jubilaciones: Que debemos saber
La presencia en nuestros estudios del Dr .Gustavo Dalinger quien habló sobre la vigencia de las Moratorias para acceder al beneficio de la Jubilación ordinaria
El municipio colabora en el control del mosquito del dengue
A partir de las 8:00, personal del Ministerio de Salud con el apoyo de la Municipalidad de Valle María comenzaron la fumigación en la vía pública con maquinaria específica en diferentes sectores de nuestra localidad donde se registran casos positivos de dengue.
Fertilizantes ciclo fina
En la editorial del día lunes el periodista Raúl Rusteholz habló del fuerte párate tecnológico de los fertilizantes ciclo fina 2024-2025
La Escuela Técnica cumplió 10 años
Este 25 de febrero, La Escuela Técnica Nº4, cumplió 10 años. Fue creada por Resolución Nº0543, en 2014.
El diálogo como herramienta para construir un país mejor
La única manera de proyectarnos como país es hacerlo en Comunidad, como lo marcan las bases partidarias que representamos y que siempre han sido nuestra bandera.
Mario Sokolovsky; Estamos trabajando para nuestra comunidad
En la mañana de hoy recibimos la vidita de Mario Sokolovsky, actual intendente de nuestra localidad quien abordó temas de actualidad.
 |
 |
 |
|
-
Add to cart
£15.00£12.00 -
£12.00Add to cart
-
£12.00Add to cart
-
£12.00Add to cart
© Copyright 2010 FM ECLIPSE 96.1. Todos los derechos reservados. Design By Gnosis